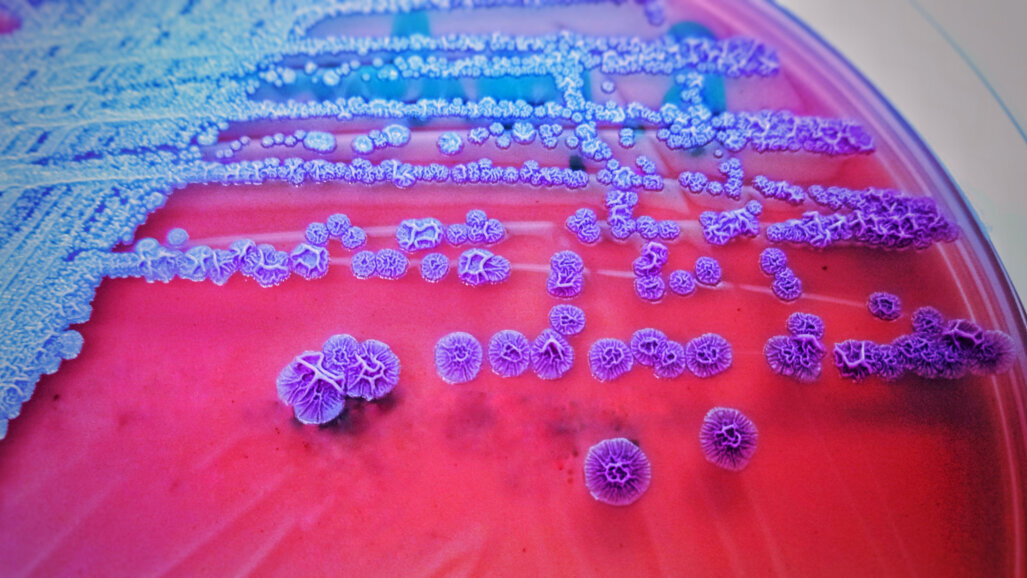
Dostupan je novi sažetak korisnih smjernica za antimikrobne recepte

LONDON, Velika Britanija: Kako bi pomogli stomatološkim timovima da kvalitetno odigraju svoju ulogu u rješavanju problema antimikrobne rezistencije, College of General Dentistry i Fakultet za dentalnu kirurgiju Kraljevskog koledža kirurga Engleske zajednički su objavili smjernice o propisivanju antibiotika u stomatologiji. Aktualno treće izdanje objavljeno je 2020. godine, a novi sinopsis preporuka za liječenje oralnih infekcija na jednoj stranici nedavno je stavljen na raspolaganje svim stomatološkim stručnjacima online.
Prema Svjetskoj zdravstvenoj organizaciji, glavni uzroci razvoja patogena otpornih na lijekove su zloupotreba i prekomjerna upotreba antibiotika, a antimikrobnu rezistenciju proglasila je jednom od deset najvećih globalnih prijetnji javnom zdravlju.
Smjernice nude jednostavne i praktične informacije o upotrebi antibiotskih lijekova za edukaciju stomatoloških timova o liječenju oralnih i stomatoloških infekcija. Novi sažetak na jednoj stranici opisuje preporučene tretmane za sedam vrsta infekcija, uključujući zubne apscese, parodontne apscese, nekrotizirajuću parodontnu bolest, akutni pulpitis i periimplantitis. Osim toga, pruža informacije o indikacijama za upotrebu antibiotika i antimikrobnom lijeku prvog izbora gdje je navedena upotreba, uključujući doze i trajanje unosa za odrasle pacijente.
Za preporuke o drugim stanjima, antibioticima drugog izbora (na primjer za pacijente koji su alergični na penicilin), dozama za djecu i hospitalizirane pacijente, liječenju medicinski ugroženih pacijenata i profilaktičkom propisivanju za sprječavanje infekcija, stomatološki timovi trebaju se pozvati na cijeli dokument.
Dr. Wendy Thompson, vodeća programerka novog sažetka i vodeća voditeljica Fakulteta opće stomatologije za upravljanje antimikrobnim lijekovima, komentirala je u priopćenju za javnost: "Razmjer problema bakterijskih infekcija otpornih na antibiotike ne može se precijeniti. Oni već ubijaju više ljudi širom svijeta od HIV-a i malarije zajedno, a uzrokovat će više smrtnih slučajeva od raka u jednoj generaciji."
Dodala je: "Propisivanjem antibiotika samo kada je to strogo potrebno, doktori dentalne medicine mogu zadržati antibiotike i na kraju spasiti živote. Upotreba novog sažetka kao pomoćnika u odlukama i pozivanje na određene smjernice po potrebi pomoći će im u tome."
Matthew Garrett, dekan Stomatološkog fakulteta Kraljevskog koledža kirurga Engleske, rekao je: "Naš novi sažetak na jednoj stranici opisuje preporuke liječenja brojnih infekcija s kojima se obično susreću doktori dentalne medicine i olakšava pristup cjelovitom, detaljnom dokumentu o smjernicama po stanjima pacijenata, koji je dostupan online u korist svih stomatoloških stručnjaka i njihovih pacijenata."
Potpune smjernice, pod nazivom Antimikrobno propisivanje u stomatologiji: smjernice za dobru praksu, dostupne su besplatno na mreži nakon registracije na mrežnoj stranici fakulteta. Sažetak na jednoj stranici dostupan je online besplatno bez registracije.
Ostali korisni alati
Osim smjernica, Visoka škola opće stomatologije izradila je Alat za samoreviziju propisivanja antibiotika s pomoću kojeg stomatološki stručnjaci mogu upravljati svojim antimikrobnim propisivanjem i mogu usporediti svoje prakse s izdanim smjernicama. Alat za reviziju objavljen je u suradnji s Britanskim stomatološkim udruženjem (BDA), a podržalo ga je Javno zdravstvo Engleske, a možete ga preuzeti ovdje.
Stomatološke ordinacije mogu pronaći dodatne informacije, resurse i alate za obuku u dentalnom antimikrobnom priručniku Toolkit, koji je razvio program stomatološke podskupine engleskog nadzora javnog zdravstva Engleske za upotrebu i otpornost na antimikrobne lijekove, Fakultet opće stomatološke ordinacije i BDA.
Pod vodstvom Njemačkog društva za očuvanje zubi (Deutsche Gesellschaft für Zahnerhaltung, DGZ) i Njemačkog društva za stomatologiju, oralnu i ...
LONDON, UK: Stomatolozi opće prakse (GDP) sada imaju jasnije preporuke na koje se mogu pozvati za uspješno praćenje i liječenje oralnih potencijalno ...
BOSTON, SAD: Oko 120 sudionika iz 27 zemalja okupilo se u Bostonu od 16. do 18. lipnja na povijesnom događaju u području dentalne implantologije – prvom...
SINGAPUR: određeni načini davanja i primjene lijekova, poput npr. rektalnih, mogu biti uznemirujući i neugodni za pacijente. Istraživači s ...
Može li augmentacija mekog tkiva oko implantata utjecati na uspjeh implantoprotetske terapije u smislu očuvanja kosti i estetike?
Odgovor na ovo pitanje ...
Istraživanje objavljeno u časopisu Journal of Dentistry potvrđuje da je sustav iTero Element 5D* s iTero NIRI (near-infrared imaging) tehnologijom ...
SEATTLE, SAD: Postojeći tretmani za preosjetljivost dentina, uključujući desenzibilizatore i blokatore dentinskih tubula, nude samo privremeno olakšanje...
NEW YORK, NY, SAD: Akutna i postoperativna stomatološka bol neizbježna je, a strategije upravljanja boli često uključuju korištenje opioida; međutim,...
SYDNEY, Australija: Istraživanja pokazuju da privlačnost lica može značajno utjecati na društvene odluke, uključujući one vezane uz izlaske, ...
MELBOURNE, Australija: Vrijednost vodice za ispiranje usta kao dijela rutinske oralne higijene često se dovodi u pitanje u literaturi. Nastojeći pružiti...
LONDON, Engleska: Znanstvenici s King’s Collegea u Londonu nedavno su objavili detalje istraživanja koje kombinira biološke uvide s najnovijom ...
Webinar uživo
uto. 23 lipnja 2026
2:00 (CET) Zagreb
Webinar uživo
uto. 23 lipnja 2026
7:00 (CET) Zagreb
Webinar uživo
uto. 23 lipnja 2026
9:00 (CET) Zagreb
Webinar uživo
sri. 24 lipnja 2026
2:00 (CET) Zagreb
Webinar uživo
sri. 24 lipnja 2026
5:00 (CET) Zagreb
Webinar uživo
sri. 24 lipnja 2026
6:30 (CET) Zagreb
Dr. med. dent. Britta Hahn
Webinar uživo
čet. 25 lipnja 2026
8:00 (CET) Zagreb
Dr. Hatem Algraffee, Cat Edney



 Austrija / Österreich
Austrija / Österreich
 Bosna i Hercegovina / Босна и Херцеговина
Bosna i Hercegovina / Босна и Херцеговина
 Bugarska / България
Bugarska / България
 Hrvatska / Hrvatska
Hrvatska / Hrvatska
 Češka i Slovačka / Česká republika & Slovensko
Češka i Slovačka / Česká republika & Slovensko
 Francuska / France
Francuska / France
 Njemačka / Deutschland
Njemačka / Deutschland
 Grčka / ΕΛΛΑΔΑ
Grčka / ΕΛΛΑΔΑ
 Mađarska / Hungary
Mađarska / Hungary
 Italija / Italia
Italija / Italia
 Nizozemska / Nederland
Nizozemska / Nederland
 Nordic / Nordic
Nordic / Nordic
 Poljska / Polska
Poljska / Polska
 Portugal / Portugal
Portugal / Portugal
 Rumunjska i Moldavija / România & Moldova
Rumunjska i Moldavija / România & Moldova
 Slovenija / Slovenija
Slovenija / Slovenija
 Srbija i Crna Gora / Србија и Црна Гора
Srbija i Crna Gora / Србија и Црна Гора
 Španjolska / España
Španjolska / España
 Švicarska / Schweiz
Švicarska / Schweiz
 Turska / Türkiye
Turska / Türkiye
 UK i Irska / UK & Ireland
UK i Irska / UK & Ireland
 Internacionalno / International
Internacionalno / International
 Brazil / Brasil
Brazil / Brasil
 Kanada / Canada
Kanada / Canada
 Latinska Amerika / Latinoamérica
Latinska Amerika / Latinoamérica
 SAD / USA
SAD / USA
 Kina / 中国
Kina / 中国
 Indija / भारत गणराज्य
Indija / भारत गणराज्य
 Pakistan / Pākistān
Pakistan / Pākistān
 Vijetnam / Việt Nam
Vijetnam / Việt Nam
 ASEAN / ASEAN
ASEAN / ASEAN
 Izrael / מְדִינַת יִשְׂרָאֵל
Izrael / מְדִינַת יִשְׂרָאֵל
 Alžir, Maroko i Tunis / الجزائر والمغرب وتونس
Alžir, Maroko i Tunis / الجزائر والمغرب وتونس
 bliski istok / Middle East
bliski istok / Middle East

To post a reply please login or register